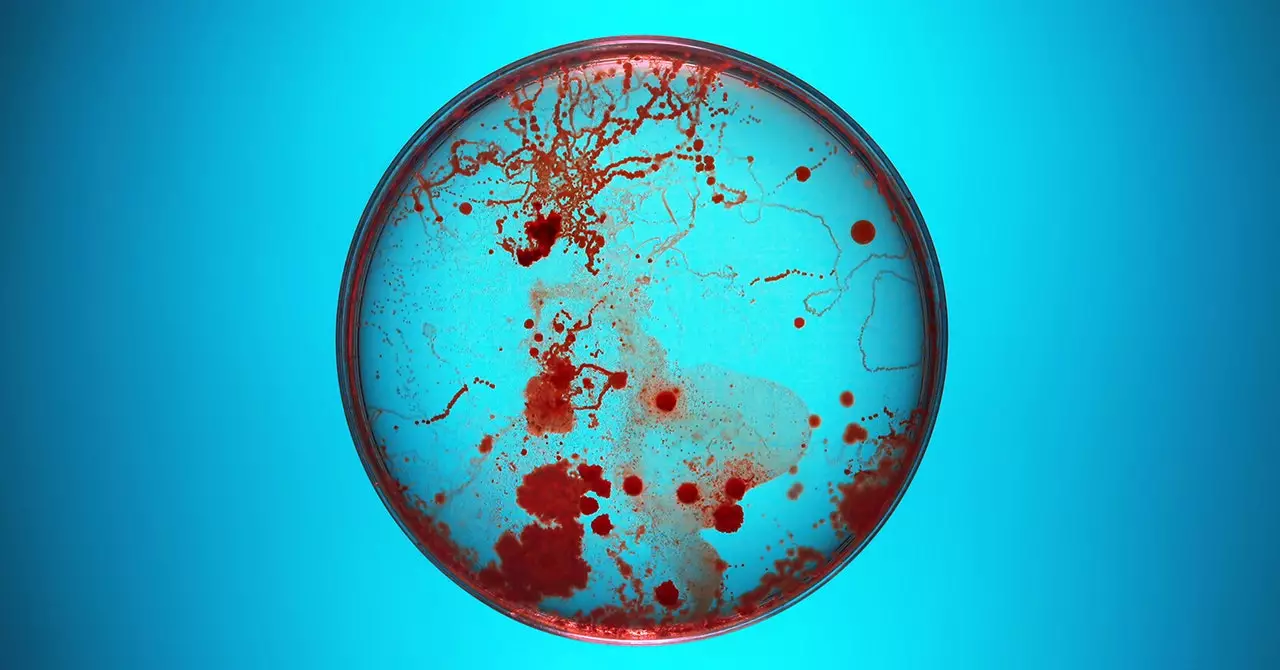
The Dangers of Biorisks in Today’s Society

As society progresses and technological advancements continue to unfold, one of the biggest concerns that experts in the field of public health and national security have is the concept of “biorisks.” These risks encompass the potential dangers associated with the misuse or unintentional release of biological agents that could result in widespread harm and devastation. With the synthesis of the first virus from scratch in 2002, the realization dawned upon the biosciences and public health communities that biology was transitioning into an engineering discipline that could be exploited for sinister purposes.
The vulnerability in society became even more apparent during the COVID-19 pandemic, which highlighted the gaps in our preparedness and response mechanisms. Jason Matheny, an expert in biosecurity, delves into the challenges faced in enhancing the security around biolabs to prevent misuse and detect biological weapons programs. Despite advancements in vaccine development and manufacturing technologies, the approval process still remains a bottleneck, hindering our ability to rapidly respond to pandemics. The rising costs of vaccines coupled with the decreasing costs of synthesizing viruses create an asymmetry that tilts the balance in favor of potential attackers.
When it comes to biorisks, there are two primary adversaries that pose significant threats. The first adversary is nature itself, with the continuous evolution of natural viruses leading to the inevitability of future viral pandemics. The economic toll of such pandemics can be astronomical, as witnessed during the COVID-19 crisis. The second adversary is intentional biological attacks, where individuals or groups with malevolent intent seek to utilize biology as a weapon. The accessibility of tools and materials necessary for such attacks has significantly increased, raising concerns about the potential misuse of emerging technologies, such as AI, in this domain.
The proliferation of advanced technologies has lowered the barriers to entry for those seeking to carry out biological attacks. The availability of DNA synthesizers, raw materials, and consumables in scientific supply stores, coupled with the potential for AI to provide ‘graduate-level training’ in bioweapon development, raises alarm bells regarding the democratization of bioterrorism. While currently, the know-how required to weaponize biological agents may still require a strong bio background, the trajectory of progress indicates a concerning trend towards making such knowledge more widely accessible.
The realm of biorisks presents a complex and challenging landscape that necessitates proactive measures to mitigate potential threats. As we navigate the intricacies of biosecurity in a rapidly evolving world, it becomes imperative to stay vigilant, adaptive, and innovative in our approach to safeguarding humanity from the perils of bioterrorism.
Leave a Reply